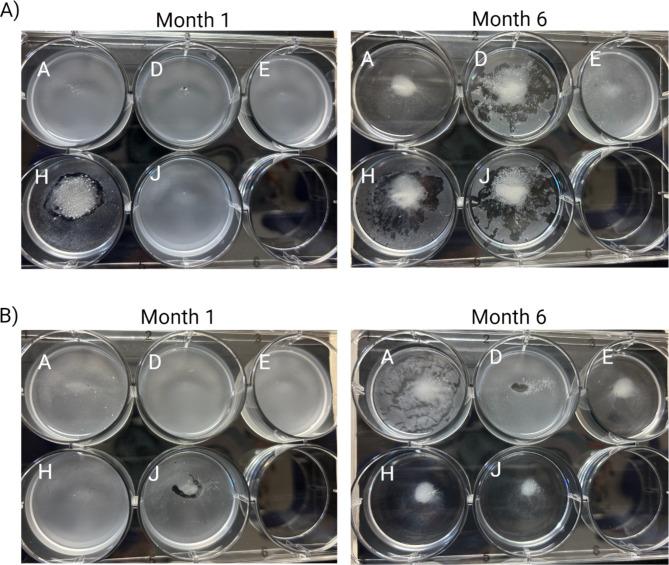
https://cdn.ncbi.nlm.nih.gov/pmc/blobs/82b8/11697318/04dcc947e06f/41598_2024_84451_Fig8_HTML.jpg

脓肿分枝杆菌克隆株暴露于粘蛋白会影响细菌表型。
Exposure of Mycobacteriodes abscessus clones to mucin affects bacterial phenotype.
作者信息
Leestemaker-Palmer Amy, Ong Tiffany, Bermudez Luiz E
机构信息
Department of Biomedical Sciences, Carlton College of Veterinary Medicine, Oregon State University, Corvallis, USA.
Department of Microbiology, College of Sciences, Oregon State University, Corvallis, USA.
出版信息
Sci Rep. 2025 Jan 2;15(1):393. doi: 10.1038/s41598-024-84451-8.
In the past 20 years infections caused by Mycobacterioides abscessus have become increasingly common in patients with chronic lung conditions. The microorganisms are also resistant to a number of antibiotic classes, making treatment challenging. To begin understanding how the bacterium adapts to the lung environment, pure colonies of M. abscessus strain 19,977 were grown in 7H9 broth with or without mucin over 30-day intervals for 6 months and analyzed for colony morphology, 7 day-growth curves, the ability to form biofilms after 14 days, and the susceptibility to antibiotics determined using previous published methods. In presence of mucin by month 3 the non-replicating stage of growth occurred by day 3, compared to earlier months. Similar characteristics were seen in colonies grown in absence of mucin by month 5. During biofilm formation, the amount of protein in the matrix started to decrease at month 3 between day 7 and day 14, with progressive overall biomass decreased in month 6. Mucin exposed clones had less of this decrease between day 7 and day 14 compared to clones naïve to mucin. The number of bacteria in the biofilms were similar in all 6 months in 7H9 medium and 7H9 with mucin. Some of the strains increased the amount of carbohydrates in the biofilm matrix overtime while others exported more DNA, the matrix containing large amounts of it. The presence of mucin was associated with increased antibiotic resistance to amikacin, 5-fold increase of MIC in 7 out of 8 strains evaluated. Some of the colonies transitioned from smooth to rough morphotypes, again indicating the influence of different environments. Overall, M. abscessus phenotype changes overtime influenced by mucin, an important component in the host lung environment. Bacteria clones arrested growth, produced different biofilms compositions, increased the resistance to antibiotics, and some changed the cell wall surfaces. These observations have direct implications in virulence and the response of the pathogen to treatment.
在过去20年中,脓肿分枝杆菌引起的感染在慢性肺部疾病患者中越来越常见。这些微生物还对多种抗生素类药物耐药,这使得治疗具有挑战性。为了开始了解这种细菌如何适应肺部环境,脓肿分枝杆菌19977菌株的纯菌落分别在添加或不添加粘蛋白的7H9肉汤中,以30天为间隔培养6个月,然后分析菌落形态、7天生长曲线、14天后形成生物膜的能力以及使用先前发表的方法测定的对抗生素的敏感性。在有粘蛋白存在的情况下,到第3个月时,与前几个月相比,生长的非复制阶段在第3天就出现了。在没有粘蛋白的情况下培养到第5个月的菌落也出现了类似特征。在生物膜形成过程中,基质中的蛋白质含量在第3个月的第7天至第14天开始下降,到第6个月时总体生物量逐渐减少。与未接触粘蛋白的克隆相比,接触粘蛋白的克隆在第7天至第14天之间这种减少较少。在7H9培养基和含粘蛋白的7H9培养基中,生物膜中的细菌数量在所有6个月中都相似。一些菌株随着时间的推移增加了生物膜基质中的碳水化合物含量,而另一些菌株则输出了更多的DNA,其基质中含有大量DNA。粘蛋白的存在与对阿米卡星的抗生素耐药性增加有关,在评估的8株菌株中有7株的最低抑菌浓度增加了5倍。一些菌落从光滑形态转变为粗糙形态,再次表明不同环境的影响。总体而言,脓肿分枝杆菌的表型随时间发生变化,受粘蛋白影响,粘蛋白是宿主肺部环境的重要组成部分。细菌克隆停止生长,产生不同的生物膜组成,增加对抗生素的耐药性,一些还改变了细胞壁表面。这些观察结果对病原体的毒力和治疗反应具有直接影响。